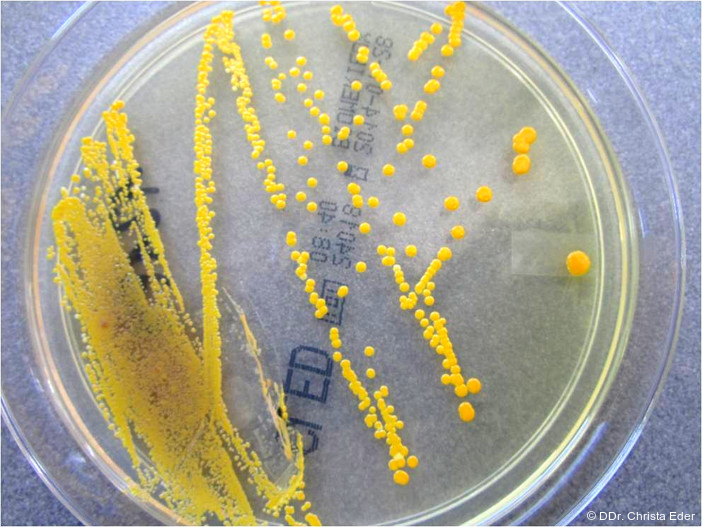

Prophylaxe 05.02.2026
Orale Candidose – ihre lokalen und systemischen Folgen
share
Candida kann in geringer bis moderater Menge bei durchschnittlich 45 Prozent der gesunden Erwachsenen und bei sogar 60 Prozent der Kinder nachgewiesen werden. Neben der häufigsten Art C. albicans findet man auch Spezies wie C. tropicalis, C. guilliermondii, C. krusei und C. parapsilosis7 (Abb. 1). Der alleinige Nachweis der Hefen ohne entsprechende Klinik ist per se nicht als pathologisch zu werten. Exo- und endogene Noxen können aber zu einer Destabilisierung der oralen Homöostase mit einem Überhandnehmen von Candida innerhalb der Biozönose führen. Die vegetativen Oidien sprossen bei Veränderungen des Biotops, wie etwa bei erhöhter Sauerstoffspannung, zu filamentösen Pseudohyphen aus. Im Gegensatz zu anderen Spezies verfügt C. albicans über spezielle Pathomechanismen25 und verursacht so 80 Prozent aller oropharyngealen Candidosen und insgesamt 50 Prozent aller Candidämien. C. albicans bildet nicht nur dickwandige resistente Dauerformen, die sogenannten Chlamydosporen, sondern auch echte septierte gewebsinvasive Hyphen. Diese Eigenschaften befähigen die Hefe zur Etablierung polymikrobieller Biofilme, in welchen sie synergistisch mit bakteriellen Erregern wie S. gordonii, S. aureus oder sogar Anaerobiern wie P. gingivalis koaggregiert und mit diesen Pathogenitäts- und Resistenzfaktoren austauscht4 (Abb. 2). Sie verfügt über lytische Enzyme, welche einen massiven inflammatorischen Respons in den Mukosazellen induzieren. Spezifische Oberflächen- und Hitzeschockproteine (Als3, Ssa1) ermöglichen Adhäsion und Invasion in tiefere Schichten des Wirtsgewebes.1 Manche Klone schützen sich sogar vor Antimykotika und lokalen Plaquehemmern, indem sie die Wirkstoffe mittels Effluxpumpen aus ihren Zellen befördern und damit unwirksam machen.
Immunschwäche triggert orale Candidose
Candidainfektionen werden vor allem durch mangelnde Entwicklung oder Reaktionsfähigkeit der lokalen und systemischen Abwehr begünstigt. So sind Säuglinge und alte Menschen, aber auch Patienten mit malignen Erkrankungen und endokrinen oder metabolischen Störungen wie Diabetes mellitus besonders anfällig für derartige Infektionen.14, 15, 23 Spezielle Risikofaktoren für die orale Candidiasis sind Xerostomie, chronische Läsionen und Ulzera sowie mechanische Irritationen der Mundschleimhaut.3 Die orale Applikation von immunsuppressiven Wirkstoffen wie Kortison bei Asthmatherapie fördert ebenfalls das Wachstum von Sprosspilzen.26
Die Abwehr von Candidainfektionen erfolgt über die T-Zellen der Lymphozyten, aber auch über Protein STAT3, welches die Exprimierung von IL-21 aktiviert und die Signalgebung an Immunzellen (B-Zellen und zytotoxische Zellen) reguliert.12 In der Mundhöhle ist vor allem der Speichelantikörper IGA ein wichtiger Schutzfaktor.19 Hyposalivation, wie beim Sjögren-Syndrom, diversen anderen Autoimmunkrankheiten, granulomatösen Läsionen der Speicheldrüsen, Diabetes mellitus und chronischen Nierenerkrankungen, führt zu einer drastischen Reduktion von IgA, welche nicht selten mit schweren, oft sogar mukokutanen Formen der Candidose einhergeht. Candidabedingte Krankheitsbilder sind Mukositis, Prothesenstomatitis, Cheilitis angularis, mediane rhomboide Glossitis, aber auch Karies sowie Parodontitis und Periimplantitis.3, 8
Candidiasis mit unterschiedlichen klinischen Bildern
Die wohl bekannteste Manifestation der Candidiasis ist die mit weißen abziehbaren Belägen einhergehende pseudomembranöse Form, der sogenannte Soor oder Trush.24 Das typische klinische Bild ist ein abziehbarer weißer Rasen mit stippchenförmigen granulierten Belägen. Im Mikroskop zeigen sich Oidien, Pseudohyphen und Hyphen sowie keratotische Debris und Entzündungszellen (Abb. 4). Im Frühstadium wird die Schleimhaut nur mäßig alteriert, später entstehen schmerzhafte Erosionen. Dann besteht Gefahr bakterieller und viraler Koinfektionen des vorgeschädigten Gewebes. Die erythematöse Form einer Candidiasis präsentiert sich mit stark geröteter Schleimhaut ohne weiße Auflagerungen (Abb. 5). Dieses eher untypische Bild wird häufig nicht sofort als Candidainfektion diagnostiziert, was eine effektive Therapie leider verzögert. Die akute Infektion manifestiert sich oft am Dorsum der Zunge und geht mit einem Verlust der Papillen einher. Die chronisch erythematöse Form, auch als atrophische Candidiasis bezeichnet, findet man vor allem an der palatinalen Mukosa von Vollprothesenträgern. Die Schleimhaut ist diffus gerötet, nicht selten liegt eine Koinfektion mit Staphylococcus aureus vor. Die betroffenen Patienten leiden unter brennenden Irritationen und oft zusätzlich unter einer Cheilitis angularis, da der Erreger mit dem Speichel auf die Mundwinkel übertragen wird.5 Der Nachweis erfolgt über einen Schleimhautabstrich mit Gramfärbung, Kultur und bei Bedarf der Erstellung eines Antimykogramms. Die chronisch hyperplastische Candidiasis30 ist oft symptomarm und nicht selten ein Zufallsbefund im Randbereich von Oberkieferprothesen. Es finden sich kleine Knötchen auf meist nur schwach gerötetem Grund. Genau diese Läsionen dürfen aber nicht unterschätzt werden, da sie in 15 bis 56 Prozent der Fälle mit schweren Zellatypien und dysplastischen Veränderungen des oralen Epithels einhergehen. Alle beschriebenen Formen können sich sowohl lokalisiert als auch generalisiert als Prothesenstomatitis manifestieren. Besonders Oberkiefervollprothesen mit Kunststoffgaumen stellen ein Reservoir für Candida dar.2
Der Sprosspilz findet unter dem Prothesenlager ideale Wachstumsbedingungen mit Wärme, Feuchtigkeit und einem großen Angebot an Nahrung vor. Die Hefe ist weitgehend vor der Spülfunktion des Speichels geschützt, kann mit passenden anderen Mikroorganismen Biofilme etablieren und Nahrungsketten aufbauen. Bei nächtlichem Tragen von Teil- oder Vollprothesen besteht Gefahr einer Aspiration der oralen Hefen. Besonders bei alten, pflegebedürftigen Patienten mit eingeschränkter Immunabwehr steigt die Gefahr einer Candida-assoziierten Pneumonie. Nach Behandlung mittels Antimykotika kommt es nicht selten kurz nach der Therapie zu einem Rezidiv der Infektion. C. albicans wächst nämlich in den rosagefärbten Kunststoff der Prothese ein und kann auch mittels der standardmäßig verwendeten Reinigungs- und Desinfektionsmittel nicht entfernt werden. Nach Eradikation von der Schleimhaut erfolgt ausgehend vom Prothesenmaterial rasch eine Reinfektion. Einzige Konsequenz ist ein Ersatz der alten Prothese nach erfolgreicher Therapie.
Candida fördert maligne Entartung von Präkanzerosen
Speziell Candida albicans hat durch ihre Fähigkeit zur Adhäsion und Invasion malignes Potenzial.18 Sie bildet Zelltoxine wie Nitrosamine und Acetaldehyd, welche Mutationen im Erbgut der oralen Epithelien auslösen können. Als Reaktion auf den fungalen Reiz kommt es zu einer Überexpression von p53, Ki-67 und COX-2 Enzymen. Die chronische Alteration und Destruktion der Mundschleimhaut bewirken einen hyperplastischen Respons. Bei Vorliegen präkanzeröser Läsionen, wie einer inhomogenen Leukoplakie oder eines Lichen planus, besteht dann ein sechsfach erhöhtes Karzinomrisiko mit hoher Tendenz zur Transformation dysplastischer Epithelien zu invasiven Plattenepithelkarzinomen10, 28 (Abb. 6). Williamson beschrieb bereits 1969 die Rolle von Candida bei der Genese oraler Plattenepithelkarzinome.29 Hier muss auch erwähnt werden, dass der Nachweis von Candida in einer weißen Veränderung der Mundschleimhaut keineswegs weitere darunterliegende, möglicherweise gefährliche Läsionen ausschließt. Candida besiedelt bevorzugt Loci minoris resistentiae. Ulzeriertes und zerfallendes Gewebe, wie etwa in Plattenepithelkarzinomen, sind ein idealer Nährboden für die Hefepilze. Jede therapieresistente „weiße Läsion“ der Mundschleimhaut muss deshalb auch bei nachgewiesener Candidainfektion histologisch abgeklärt werden.
Candida albicans steht auch in enger Beziehung zu Karies und Parodontitis.6, 13 In parodontalen Taschen ist sie im subgingivalen Biofilm synergistisch mit den typischen Anaerobiern an der Destruktion des Zahnhalteapparates beteiligt. Bei geplanter Antibiose im Rahmen einer zahnärztlichen Intervention sollte eine mögliche Beteiligung von Hefen unbedingt abgeklärt werden, da unter einer rein bakteriziden Therapie Gefahr einer Überwucherung durch Candida besteht. In kariösen Läsionen fördert der Synergismus zwischen Lactobacillus und Candida die Zerstörung der Hartgewebe der Zähne. Für die Therapie symptomatischer oraler Läsionen kommen vor allem Antimykotika von Azol- oder Polyentyp wie Nystatin, Miconazol, Clotrimazol oder Amphotericin B in Form topischer Mundgels oder Lutschtabletten zum Einsatz.16 Systemische Therapien sollten nur im interdisziplinären Kontext, bei Beteiligung mehrerer Organe oder bei schweren Formen der Immunschwäche wie AIDS in Absprache mit dem die Grunderkrankung behandelnden Facharzt verabreicht werden.17
Interdisziplinäre Aspekte einer oralen Candidose
Bei Patienten mit gastroösophagealen Refluxerkrankungen (GERD) ist der pH-Wert in der Mundhöhle durch den aufsteigenden Magensaft im sauren Bereich. Zusätzlich kommt es bei GERD zu einer paradoxen Hyposalivation und in der Folge zu Xerostomie. Beide Faktoren fördern das Wachstum und die Invasion von C. albicans. Aus den mit Candida angereicherten oralen Biofilmen werden laufend kleine Fetzchen abgelöst, verschluckt und infizieren das durch die Magensäure bereits geschädigte Gewebe der Speiseröhre. Es kommt zu einer Soorösophagitis, welche ihrerseits, rückwirkend über den Reflux, die Reinfektion der oralen Weichgewebe verstärkt22, 25 (Abb. 7).
Candida kann problemlos die Säureschranke des Magens überwinden, bis in den Darm gelangen und sich dort im intestinalen Mikrobiom etablieren. Bei 70 Prozent der gesunden Erwachsenen ist Candida in geringen Mengen im Stuhl nachweisbar. Eine überproportionale, durch eine orale Infektion getriggerte Zunahme von C. albicans kann aber die positive Interaktion der Hefe mit dem lokalen Immunsystem des Darmes stören und zu einer Dysbiose führen. Dieser organübergreifende Komplex wird als „Candida Hypersensitive Syndrome“ bezeichnet und steht in engem Zusammenhang mit dem Reizdarmsyndrom, dem Chronic Fatigue Syndrom (CFS) und sogar mit chronisch entzündlichen Darmerkrankungen wie M. Crohn und Colitis ulzerosa.11, 21
Die richtige Einschätzung eines klinischen und mikrobiologischen Nachweises von Candida im Rahmen oraler und systemischer Erkrankungen ist die Voraussetzung für eine adäquate Therapie und damit für die Wiederherstellung der Integrität der Mikrobiome unseres Körpers.